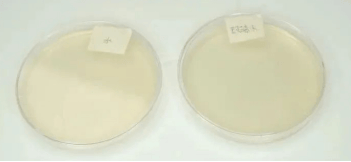

行车安全的“第一道防线”为何频频失守?
清晨启程,前挡风玻璃上却蒙着一层薄薄的油膜;雨夜疾驰,雨水与污渍交织成斑驳的光晕;高速飞驰后,虫胶与灰尘顽固地附着于玻璃,雨刮刮过只留下一道道水痕……这些场景是否让你倍感困扰?许多车主为图方便,直接使用自来水或廉价玻璃水,结果却埋下隐患:自来水不仅无法清除油污,长期使用更会滋生细菌、产生水垢,甚至引发健康风险。研究表明,司机因使用自来水替代玻璃水而感染军团菌病的概率是普通人的5倍。更严重的是,普通液体缺乏润滑性,会加速雨刮胶条老化,导致刮拭噪音刺耳、玻璃划伤,直接威胁行车安全。

面对这一痛点,顶刮刮玻璃水以“功能单一”的传统产品为革新对象,通过七大核心科技,将清洁、防护、安全与体验融合为一套完整的解决方案。本文将通过实验数据、成分分析与场景化解读,揭开顶刮刮如何以科技重塑玻璃水的价值边界。
第一章:隐患重重的“省事”选择——自来水为何成为隐形杀手?
越刮越糊:清洁力不足的视觉陷阱
实验显示,自来水对油污、虫胶等顽固污渍的清洁力几乎为零。当雨水或灰尘与玻璃表面的油膜混合时,会形成一层散射光线的膜状物,使视野模糊不清。尤其在夜间行车时,对向车灯的眩光会被油膜放大,进一步增加驾驶风险。

健康威胁:细菌滋生与军团菌风险
英国健康防护局研究发现,汽车玻璃水箱中若长期使用自来水,易成为军团菌的“培养皿”。这类细菌通过喷洒出的水雾传播,吸入后可能引发类似肺炎的病症。顶刮刮的对比实验显示,其含有的卡松杀菌剂可完全抑制细菌生长,而自来水培养皿在3天后已菌落遍布。
机械损伤:水垢堵塞与部件腐蚀
自来水中的钙镁离子会形成水垢,堆积在喷孔及管路中,导致堵塞或喷射压力不足。更严重的是,普通液体的酸碱度不稳定,可能加速雨刮胶条硬化、金属部件锈蚀。顶刮刮的去离子水与pH智能锁存技术,从根本上杜绝了此类问题。
第二章:七重科技深度解读——顶刮刮如何精准狙击痛点?
医用级去离子水:从源头守护管路健康
50层过滤工艺:彻底去除杂质与离子,确保零水垢、零沉淀。
抑制螯合反应:防止雨水中的金属离子在玻璃表面形成难溶污垢,持久保持透亮。
纳米靶向去污因子:5秒乳化顽固污渍
乙醇+三乙醇胺协同配方:乙醇作为有机溶剂快速溶解油垢,三乙醇胺进一步分解胶质,实现“刮拭即净”。
专为尾气油膜设计:城市行车中,尾气颗粒易附着玻璃形成油膜,顶刮刮的活性成分可靶向剥离这类顽固污渍。
橡胶活化剂:雨刮寿命提升50%
降低70dB噪音:通过润滑胶条与玻璃的摩擦界面,减少刮拭异响。
278款车型验证:适配不同雨刮压力与弧度,避免因胶条硬化导致的刮不净或跳刷。
pH智能锁存技术:零腐蚀配方
弱碱性稳定区间(pH 6.8–7.2):符合国标要求,兼顾去污力与温和性,对胶条、金属、车漆无损伤。
卡松杀菌防护:水壶洁净无忧
微生物抑制实验:对比显示,顶刮刮培养皿无菌落形成,而自来水培养皿菌落遍布。
军团菌风险防控:直接针对司机高发感染问题,确保喷洒出的水雾洁净安全。

宽温域防冻抗沸:-30℃至45℃全境覆盖
中国全域气候适配:北方严寒不冻结,南方酷暑不失效,避免因温度变化导致的性能衰减。
瑞士香氛微胶囊技术:刮拭留香体验
桂花清香替代刺鼻气味:微胶囊技术在刮拭时破裂释放淡雅香气,提升驾驶心情。

第三章:实验与场景化验证——数据背后的安全承诺
去污力对比实验
模拟顽固污渍测试:顶刮刮在5秒内乳化油膜,刮后玻璃透光率提升90%,而自来水组残留明显水痕。
虫胶清除测试:顶刮刮一次刮拭清除率达95%,普通玻璃水需多次喷射且残留胶质。
极端环境适应性测试
-30℃冷冻实验:顶刮刮保持液态流动,普通玻璃水已凝固成冰。
45℃高温暴晒:顶刮刮成分无分离、无挥发,性能稳定。
长期使用跟踪
雨刮胶条磨损对比:使用顶刮刮的车辆,雨刮胶条一年后无裂纹、弹性保持率超90%。
喷孔堵塞统计:自来水用户年均堵塞概率为23%,顶刮刮用户仅为0.3%。
第四章:何时更需要顶刮刮?——多场景使用指南
长途自驾前:添加顶刮刮,应对多变的道路环境与虫胶侵袭。
雨季来临前:强效除油膜,避免雨水与污渍混合形成的“马赛克视野”。
冬季低温时:-30℃防冻保障,北方车主无需担心水箱冻裂。
日常通勤中:润滑雨刮、抑制细菌,让每一次刮拭都静音且健康。

第五章:车主自检指南——你的玻璃水选对了吗?
水垢检测:玻璃水存放后是否有沉淀?顶刮刮去离子水无杂质析出。
清洁力评估:雨天是否越刮越糊?顶刮刮纳米因子可瞬间清除油膜。
气味判断:喷洒后是否有刺鼻化学味?顶刮刮采用食品级香氛。
防冻性能验证:冬季是否结冰?顶刮刮-30℃仍保持流动性。
结语:清晰视野,是安全驾驶的基石
顶刮刮玻璃水以科技重塑行业标准,从“清洁”升级为“养护+安全+体验”的综合解决方案。选择顶刮刮,即是选择对爱车的长效呵护,对每一次出行的责任与安心。
本文内容基于实验数据与产品实测,部分场景案例来源于车主调研。建议定期检查雨刮状态,并根据地区气候选择适配型号





